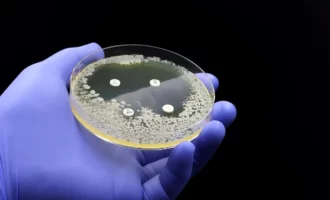
یک محیط کشت حاوی باکتری و آنتی‌بیوتیک برای سنجش مقاومت به آنتی‌بیوتیک

بیماری
درباره بیماریها در اینجا می نویسیم. از بیماریهای کمتر شناخته شده ای مانند بیماری لوپوس و بیماری پروانه ای تا بیماریهای نام آشنایی چون بیماری قلبی، عروقی، کبد و کلیه و سایر اندام بدن انسان. سلامتی شاید برای شما مهم تر باشد.
آخرین مطالب
-
سلامت تحقیق جدید: آلاینده سوختهای فسیلی با افزایش ریسک بیماری ALS رابطه دارد
تحقیق جدید ارتباطی بین قرارگرفتن در معرض آلاینده دیاکسید گوگرد و افزایش خطر ابتلا به بیماری ALS پیدا کرده است.
![آلاینده سوختهای فسیلی]() ۱۵ مهر ۱۴۰۴
۱۵ مهر ۱۴۰۴
-
علمی هشدار دانشمندان: سشوار و اتو مو میلیاردها نانوذره خطرناک وارد ریه میکنند
طبق این تحقیق، هنگام حرارت دیدن محصولات مو، ترکیبات سیلیکونی بخار شده و به نانوذرات بسیار ریز خطرناکی تبدیل میشوند.
![سشوار]() ۲ شهریور ۱۴۰۴
۲ شهریور ۱۴۰۴
-
سلامت سندروم کوشینگ چیست؟ علت و علائم + روشهای درمان
در این مقاله با سندرم کوشینگ آشنا خواهید شد و همچنین علائم بالینی و روشهای درمان سندرم کوشینگ را خواهید شناخت.
![]() ۱ مرداد ۱۴۰۴
۱ مرداد ۱۴۰۴
-
سلامت گام بزرگ برای درمان HIV؛ استفاده از mRNA برای نمایانسازی ویروس
این مطالعه با هدف حل یکی از بزرگترین چالشها در درمان HIV، یعنی مخفیشدن ویروس در برخی سلولها انجام شده است.
![درمان HIV]() ۱۵ خرداد ۱۴۰۴
۱۵ خرداد ۱۴۰۴
-
سلامت چرا بیماریها بر زنان و مردان اثر متفاوتی دارند؟ تحقیق جدید دانشمندان پاسخ میدهد
طبق این تحقیق، نقش ژنتیک در بروز این تفاوتها آنچنان بزرگ نیست.
![تفاوت بیماریها]() ۱۱ خرداد ۱۴۰۴
۱۱ خرداد ۱۴۰۴
-
سلامت سازمان غذا و داروی آمریکا نخستین آزمایش خون برای تشخیص آلزایمر را تأیید کرد
این آزمایش با بررسی نسبت 2 پروتئین موجود در خون، به تشخیص علائم وجود پلاکهای آمیلوئید بتا در مغز کمک میکند.
![آلزایمر]() ۲۸ اردیبهشت ۱۴۰۴
۲۸ اردیبهشت ۱۴۰۴
-
سلامت ریه پاپکُرنی؛ بیماری خطرناکی که میتواند با کشیدن ویپ پدید آید
این بیماری با ایجاد آسیبهای برگشتناپذیر به ریه شما باعث بروز مشکلاتی میشود که هیچ درمانی برای آن وجود ندارد.
![ویپ]() ۱۴ اردیبهشت ۱۴۰۴
۱۴ اردیبهشت ۱۴۰۴
-
سلامت دیابت نوع 5 به رسمیت شناخته شد؛ شکل جدید بیماری که با چاقی مرتبط نیست
دیابت نوع 5 بیشتر در کشورهای با درآمد پایین و بین نوجوانان مبتلا به سوءتغذیه دیده میشود.
![دیابت نوع 5]() ۱ اردیبهشت ۱۴۰۴
۱ اردیبهشت ۱۴۰۴
-
سلامت یافته محققان کانادایی: موز میتواند فشار خون را کاهش دهد
طبق این تحقیق، مصرف غذاهای سرشار از پتاسیم مانند موز و بروکلی، تأثیر قابلتوجهی در تنظیم فشار خون دارد.
![]() ۲۸ فروردین ۱۴۰۴
۲۸ فروردین ۱۴۰۴
-
سلامت باورهای غلط پیرامون ADHD؛ نگاهی دقیقتر به یکی از شایعترین اختلالهای عصبی
در این مطلب با مرور پژوهشهای مختلف، نگاه دقیقتری به اختلال ADHD میاندازیم.
![اختلال ADHD]() ۲۶ فروردین ۱۴۰۴
۲۶ فروردین ۱۴۰۴
-
سلامت مطالعه جدید: مصرف دوز بالای ویتامین دی شاید پیشرفت بیماری اماس را آهسته کند
دانشمندان در پژوهش بالینی جدیدی دریافتند مصرف ویتامین دی با دوز بالا میتواند فعالیت بیماری اماس را کاهش دهد.
![ویتامین دی]() ۶ فروردین ۱۴۰۴
۶ فروردین ۱۴۰۴
-
سلامت تحقیق جدید: تنها ۵ روز مصرف غذاهای ناسالم احتمال چاقی را افزایش میدهد
مصرف ۵ روزه غذاهای ناسالم حساسیت مغز به انسولین را کاهش میدهد، روندی که حتی پس از بازگشت به رژیم عادی ادامه دارد.
![چاقی]() ۱ فروردین ۱۴۰۴
۱ فروردین ۱۴۰۴
-
سلامت درمان ابولا با یک قرص؛ آزمایش روی میمونها با نتایج امیدوارکننده همراه شد
پژوهش جدید نشان میدهد یک قرص خوراکی میتواند ابولا را درمان و راه را برای درمانهای عملیتر و مقرونبهصرفهتر هموار کند.
![درمان ابولا]() ۲۸ اسفند ۱۴۰۳
۲۸ اسفند ۱۴۰۳
-
سلامت شیوع جهانی بیماری سرخک؛ افزایش شدید موارد ابتلا در آمریکا و اروپا
کاهش سطح واکسیناسیون پس از همهگیری کرونا باعث افزایش بیسابقه موارد سرخک در آمریکا و اروپا شده است.
![شیوع سرخک]() ۲۶ اسفند ۱۴۰۳
۲۶ اسفند ۱۴۰۳
-
سلامت گام بزرگ محققان به سوی درمان پارکینسون؛ کشف ساختار پروتئین دخیل در بیماری
کشف ساختار پروتئین PINK1 و مکانیسم آن در پارکینسون امیدی تازه برای درمان این بیماری عصبی ایجاد میکند.
![پارکینسون]() ۲۶ اسفند ۱۴۰۳
۲۶ اسفند ۱۴۰۳
-
سلامت مطالعه جدید: دیابت میتواند مقاومت به آنتیبیوتیک را افزایش دهد
مطالعهای جدید نشان میدهد بیماری دیابت میتواند موجب جهشهای ژنتیکی در باکتریها شود که مقاومت به آنتیبیوتیک ایجاد میکند.
![یک محیط کشت حاوی باکتری و آنتیبیوتیک برای سنجش مقاومت به آنتیبیوتیک]() ۱۱ اسفند ۱۴۰۳
۱۱ اسفند ۱۴۰۳
-
سلامت شیوع بیماری کشنده در اثر خوردن خفاش؛ مرگ بیش از 50 نفر در کنگو گزارش شد
این بیماری ناشناخته ظاهراً فرد را در عرض 48 ساعت میکشد.
![بیماری جدید در کنگو در اثر خوردن خفاش]() ۸ اسفند ۱۴۰۳
۸ اسفند ۱۴۰۳
-
سلامت دستاورد محققان چینی: ساخت گونهای از برنج که میتواند به سلامت قلب کمک کند
دانشمندان چینی با ویرایش ژنتیکی برنج، مولکولی را در آن افزایش دادهاند که میتواند به کاهش خطر بیماریهای قلبی کمک کند.
![]() ۴ اسفند ۱۴۰۳
۴ اسفند ۱۴۰۳
-
سلامت تحقیق جدید: آلودگی هوا عملکردهای شناختی را مختل و فعالیتهای روزانه را دشوار میکند
آلودگی هوا نهفقط به بدن آسیب میزند، بلکه تواناییهای شناختی را کاهش میدهد و در فعالیتهایی مانند خرید و تصمیمگیری مؤثر است.
![آلودگی هوا]() ۲۰ بهمن ۱۴۰۳
۲۰ بهمن ۱۴۰۳
-
سلامت محققان اسکاتلندی: آلودگی هوا با افزایش بیماریهای روانی ارتباط دارد
به گفته محققان آلایندههایی مانند دیاکسید نیتروژن با بستریشدن افراد در بیمارستان سلامت روان مرتبط است.
![آلودگی هوا و سلامت روان]() ۶ دی ۱۴۰۳
۶ دی ۱۴۰۳

همچنین میتوانید جهت آگاهی از آخرین اخبار در حوزه تکنولوژی و اطلاع از بروزرسانی دیجیاتو مارا در شبکههای اجتماعی زیر نیز دنبال کنید. خوشحالیم که همراه ما هستید.